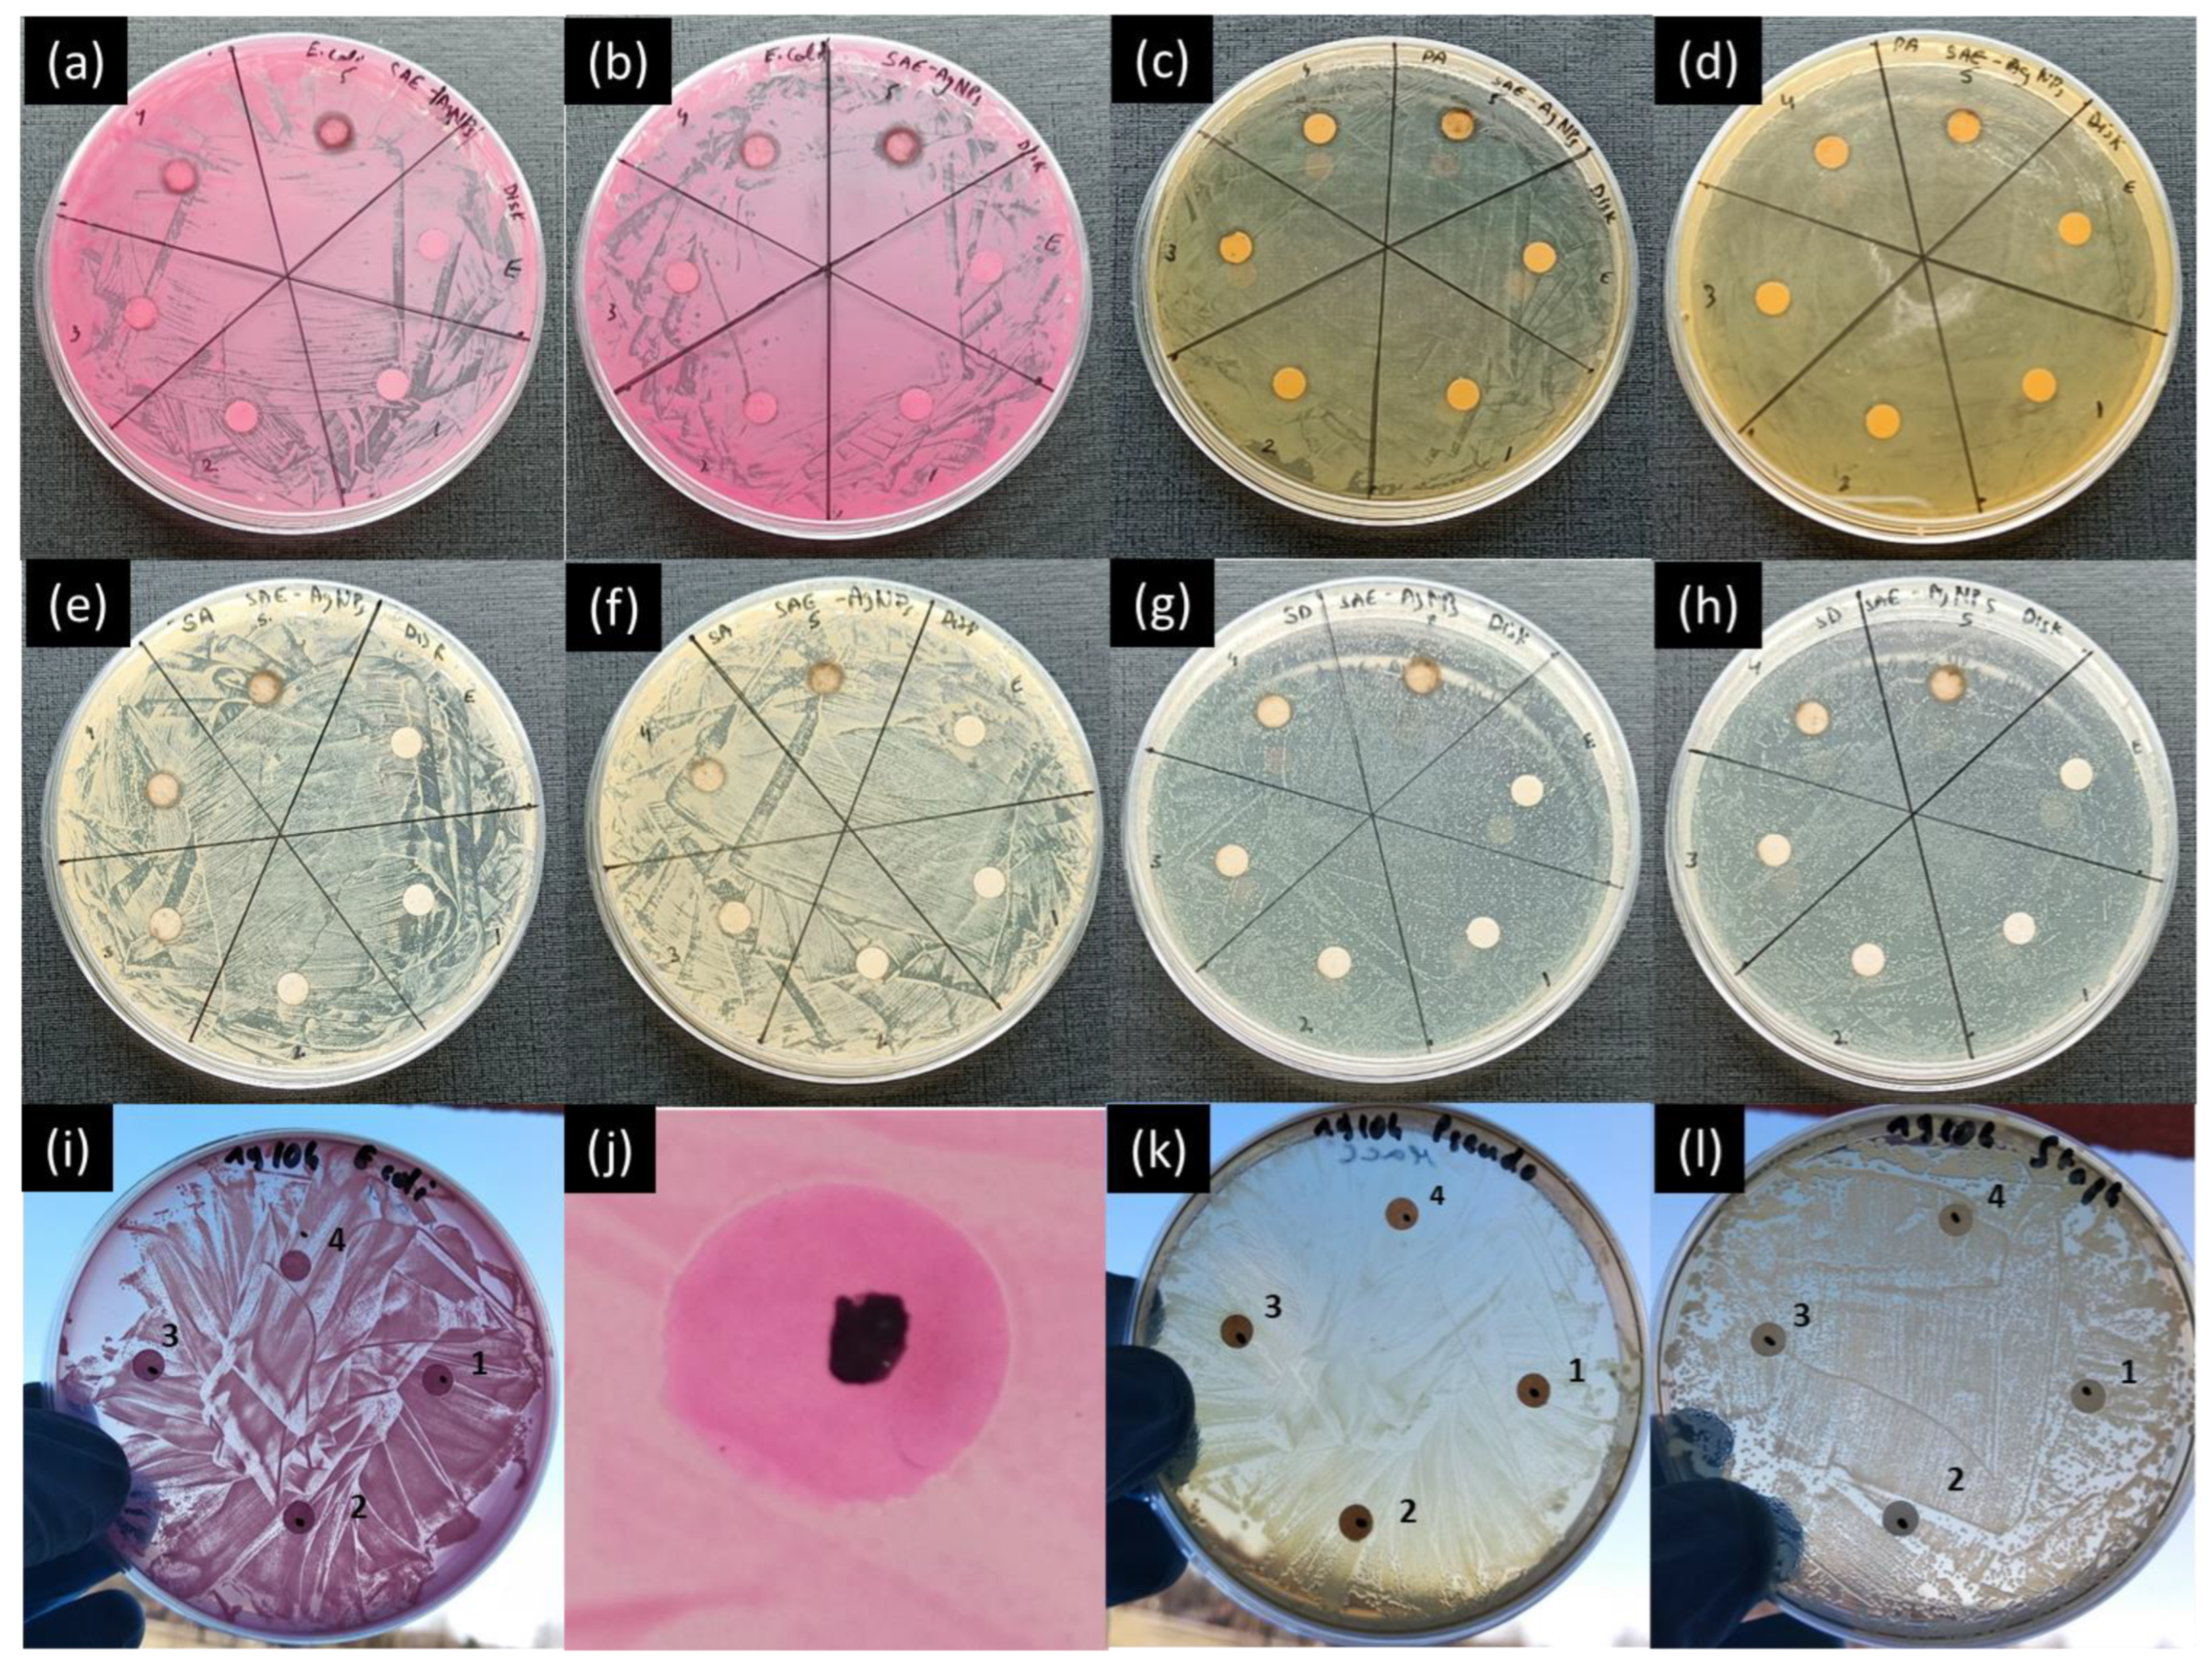
Ijms 25 05599 g004
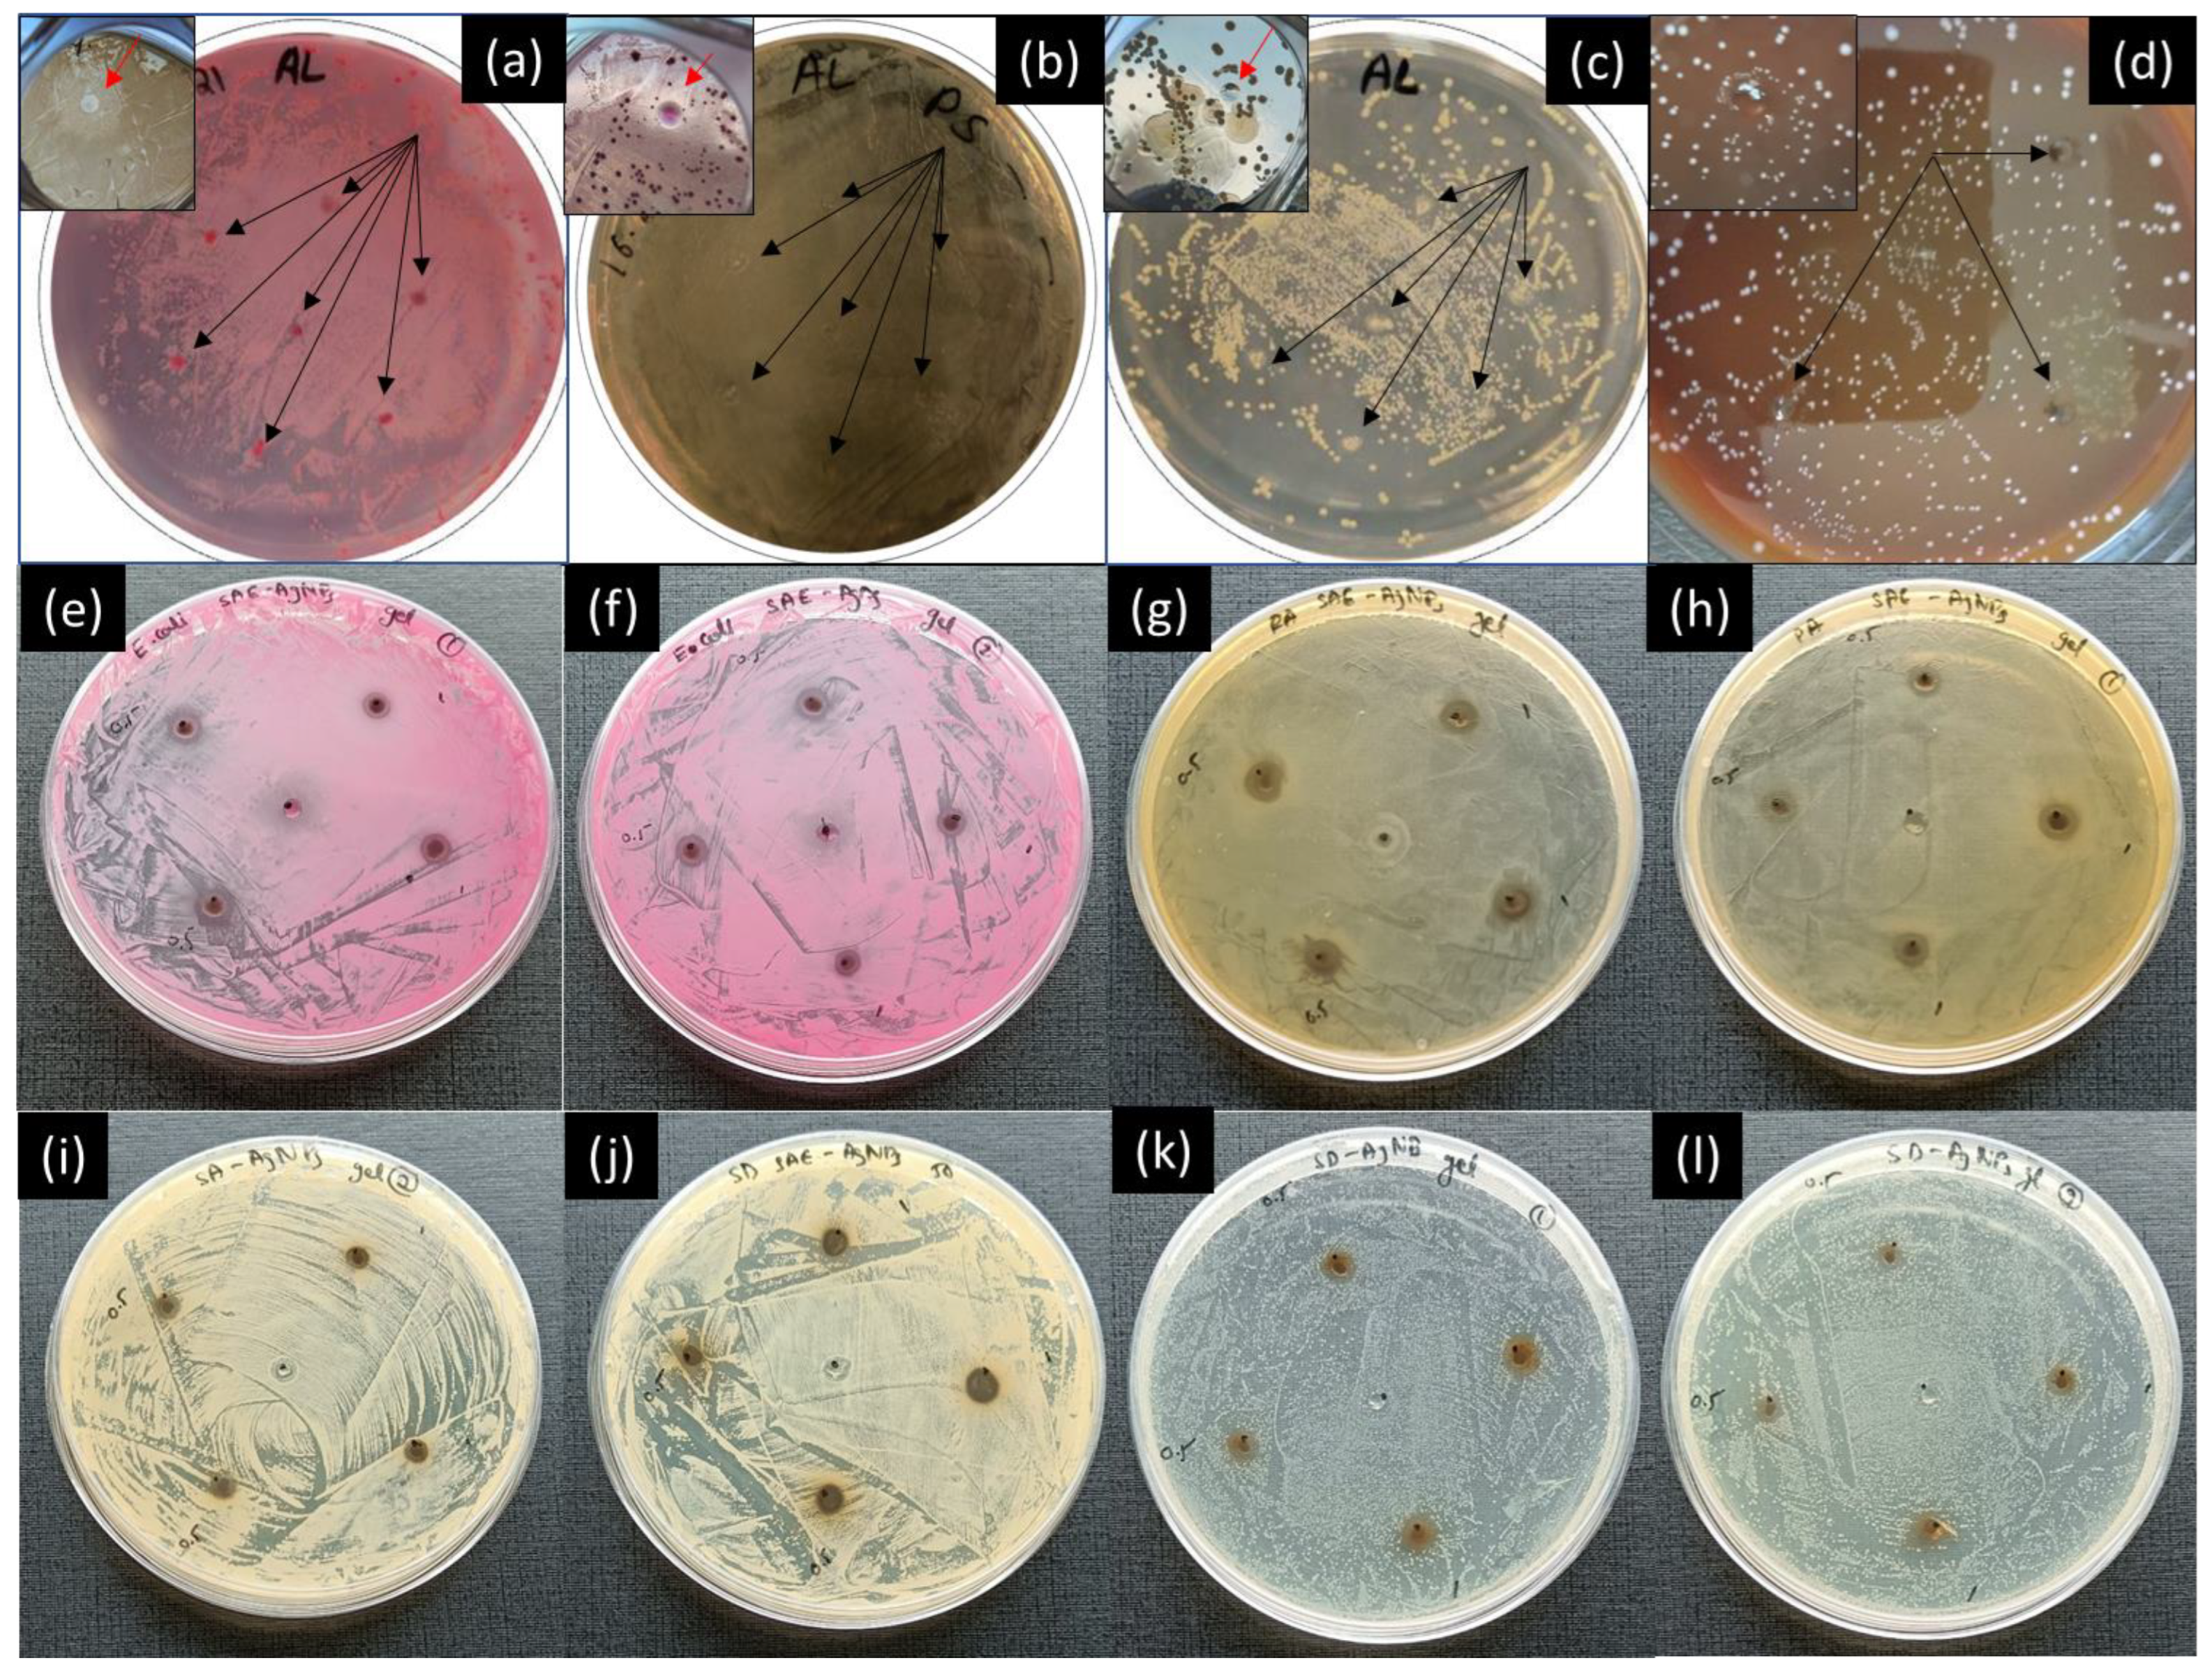
Ijms 25 05599 g005
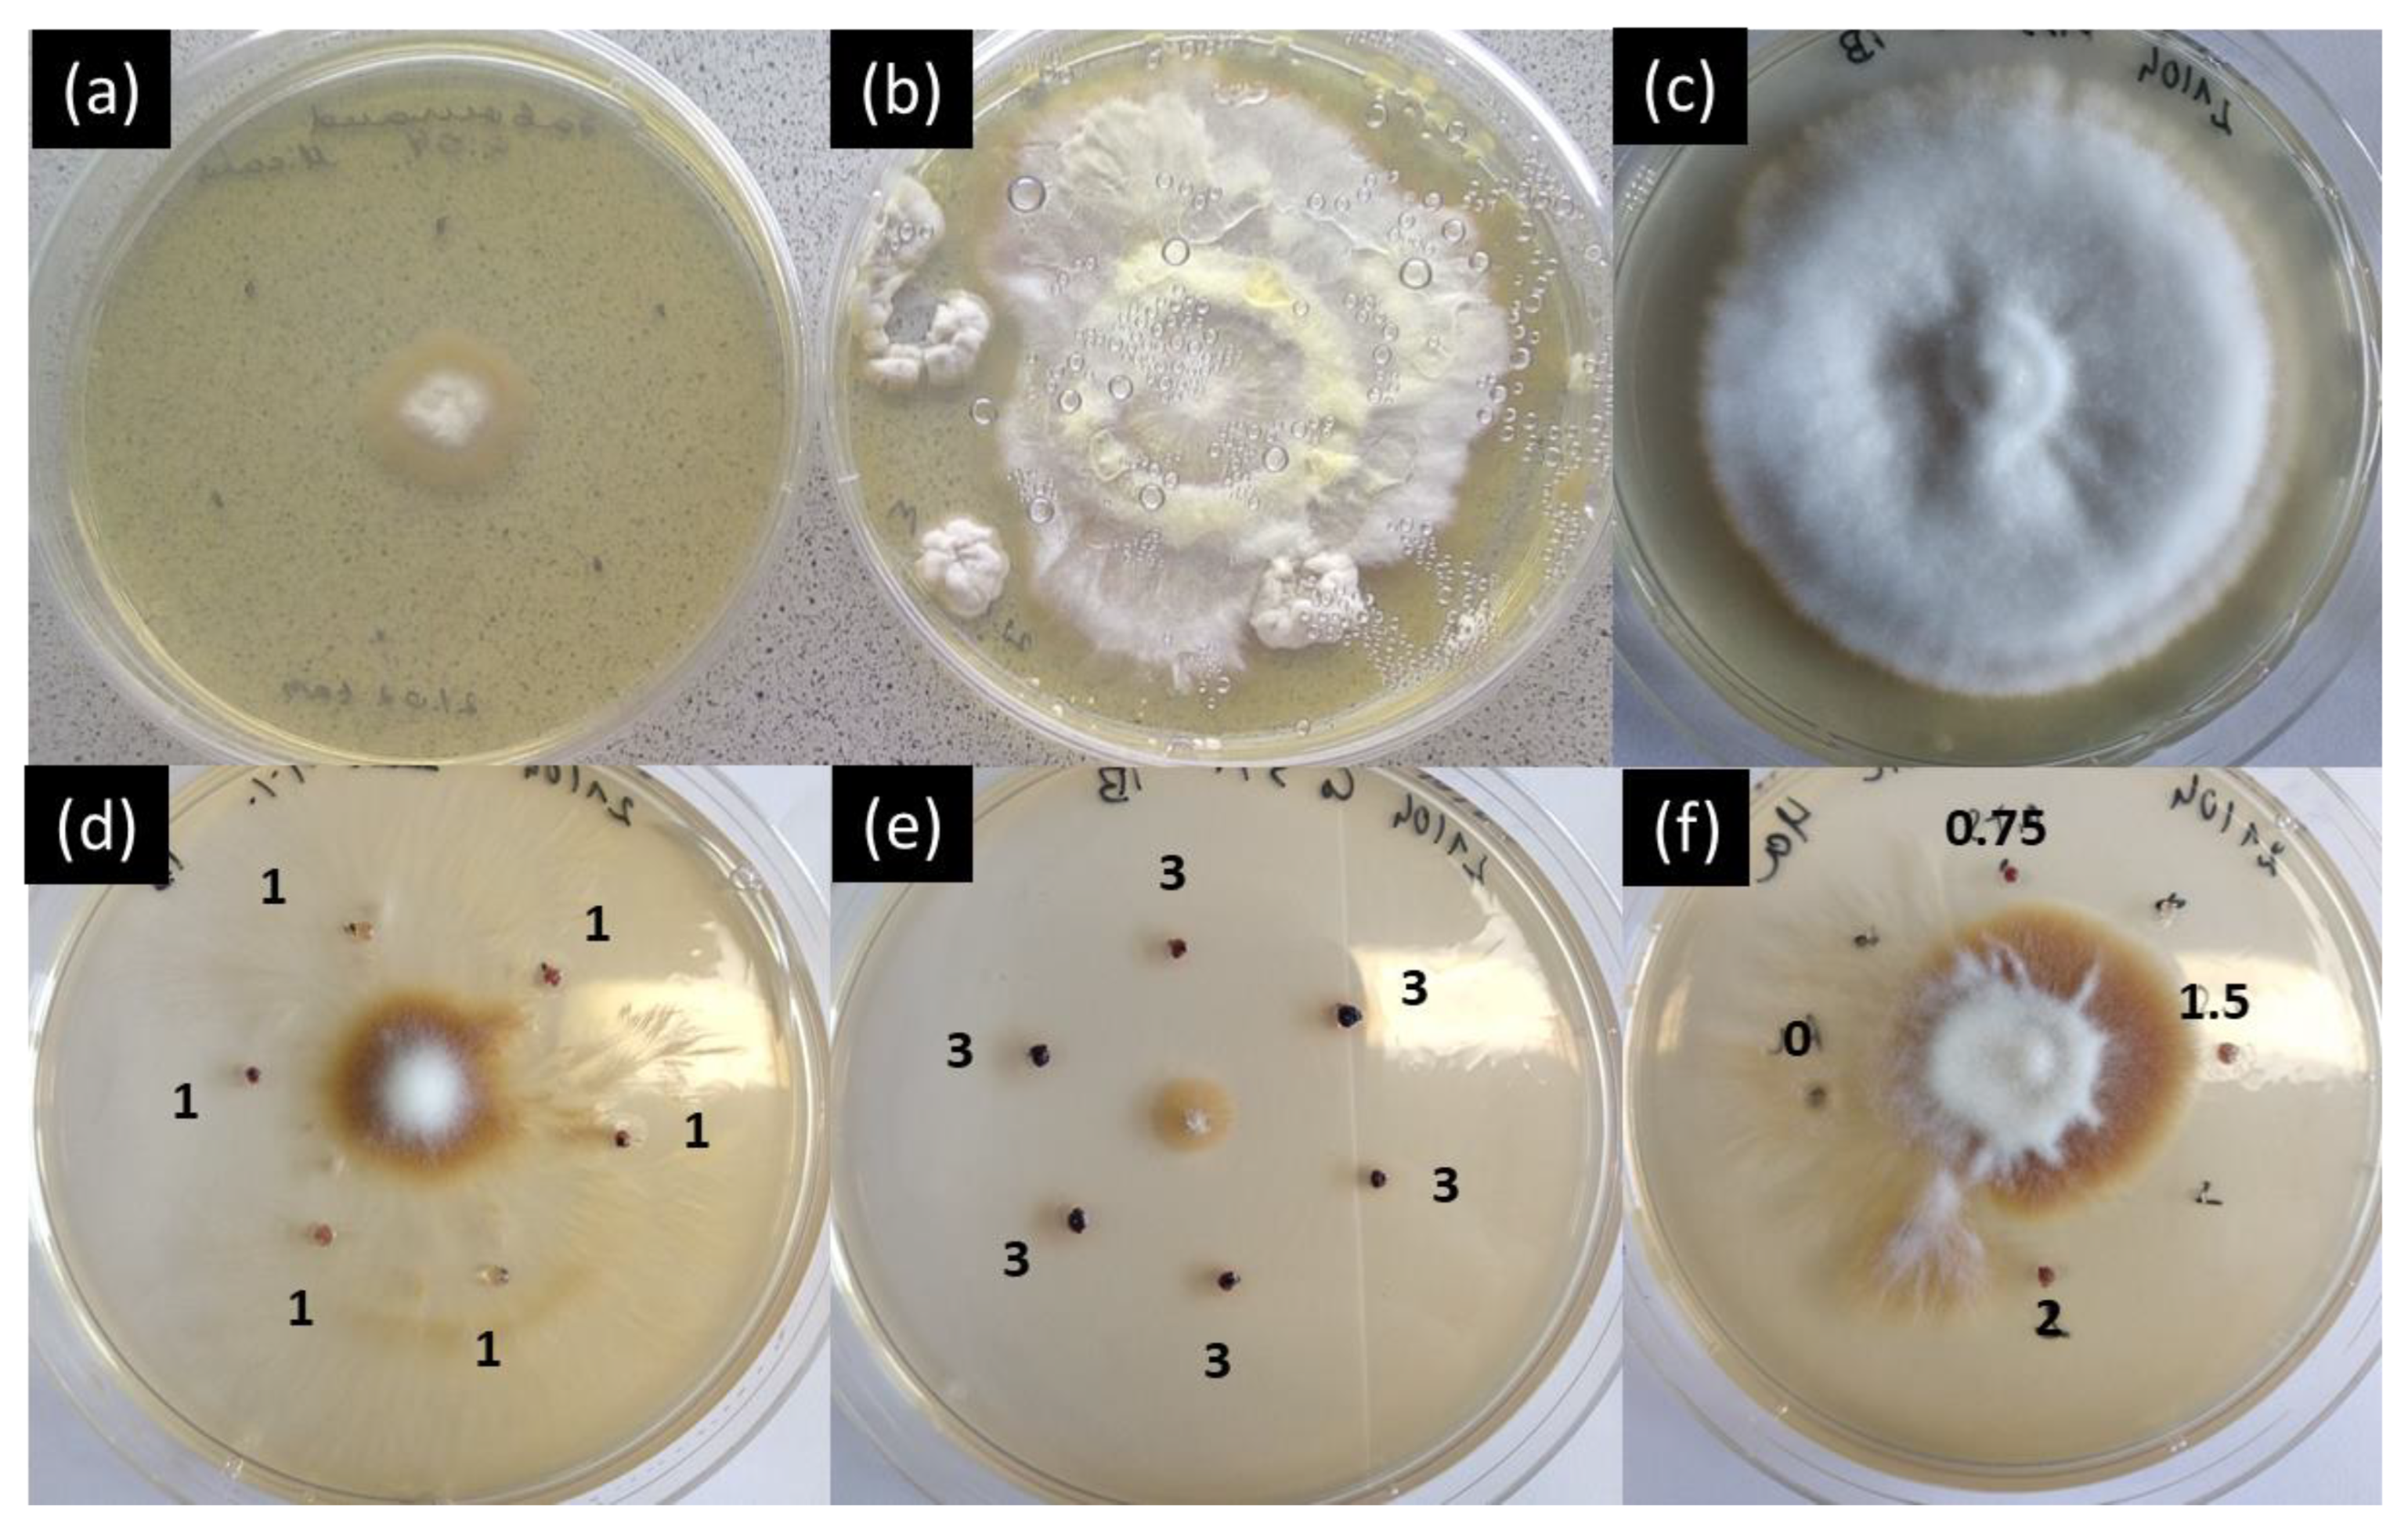
Ijms 25 05599 g008

Use of Aloe Vera Gel as Media to Assess Antimicrobial Activity and Development of Antimicrobial Nanocomposites
Abstract
1. Introduction
2. Results and Discussion
2.1. Characterization of the Nanomaterials
2.2. Evaluation of Antibacterial Activity
2.2.1. Drop Diffusion Assay
2.2.2. Well Diffusion Assay
2.2.3. Disk Diffusion Assay
2.2.4. Gel Diffusion Assay
2.3. Comparison between Drop Diffusion Assay and Gel Diffusion Assay
2.3.1. Antimicrobial Tests against Bacterial Strains: Silver Nanoparticles
2.3.2. Antimicrobial Tests against Fungal Strain: Cobalt Nanoparticles
3. Materials and Methods
3.1. Materials
3.2. Nanomaterials
3.3. Experimental Details
3.3.1. Characterization of the Nanoparticles
3.3.2. Antimicrobial Properties Assay
- Drop diffusion assay
- Well diffusion assay
- Disk diffusion assay
- Aloe Vera gel diffusion assay
4. Conclusions
Supplementary Materials
Author Contributions
Funding
Institutional Review Board Statement
Informed Consent Statement
Data Availability Statement
Acknowledgments
Conflicts of Interest
References
- Djordjevic, S.P.; Jarocki, V.M.; Seemann, T.; Cummins, M.L.; Watt, A.E.; Drigo, B.; Wyrsch, E.R.; Reid, C.J.; Donner, E.; Howden, B.P. Genomic surveillance for antimicrobial resistance—A One Health perspective. Nat. Rev. Genet. 2023, 25, 142–157. [Google Scholar] [CrossRef]
- Burki, T.K. Development of new antibacterial agents: A sense of urgency needed. Lancet Respir. Med. 2021, 9, e54. [Google Scholar] [CrossRef] [PubMed]
- Lockhart, S.R.; Chowdhary, A.; Gold, J.A.W. The rapid emergence of antifungal-resistant human-pathogenic fungi. Nat. Rev. Microbiol. 2023, 21, 818–832. [Google Scholar] [CrossRef] [PubMed]
- Rizwana, H.; Aljowaie, R.M.; Al Otibi, F.; Alwahibi, M.S.; Alharbi, S.A.; Al asmari, S.A.; Aldosari, N.S.; Aldehaish, H.A. Antimicrobial and antioxidant potential of the silver nanoparticles synthesized using aqueous extracts of coconut meat (Cocos nucifera L.). Sci. Rep. 2023, 13, 16270. [Google Scholar] [CrossRef] [PubMed]
- Davis, S.A.; Vincent, B.M.; Endo, M.M.; Whitesell, L.; Marchillo, K.; Andes, D.R.; Lindquist, S.; Burke, M.D. Nontoxic antimicrobials that evade drug resistance. Nat. Chem. Biol. 2015, 11, 481–487. [Google Scholar] [CrossRef] [PubMed]
- Kaur, H.; Rauwel, P.; Rauwel, E. Chapter 6—Antimicrobial nanoparticles: Synthesis, mechanism of actions. In Antimicrobial Activity of Nanoparticles; Guisbiers, G., Ed.; Elsevier: Amsterdam, The Netherlands, 2023; pp. 155–202. [Google Scholar] [CrossRef]
- Küünal, S.; Kutti, S.; Rauwel, P.; Guha, M.; Wragg, D.; Rauwel, E. Biocidal properties study of silver nanoparticles used for application in green housing. Int. Nano Lett. 2016, 6, 191–197. [Google Scholar] [CrossRef]
- Saravanan, A.; Kumar, P.S.; Karishma, S.; Vo, D.-V.N.; Jeevanantham, S.; Yaashikaa, P.R.; George, C.S. A review on biosynthesis of metal nanoparticles and its environmental applications. Chemosphere 2021, 264, 128580. [Google Scholar] [CrossRef] [PubMed]
- Rauwel, P.; Rauwel, E.; Ferdov, S.; Singh, M.P. Silver Nanoparticles: Synthesis, Properties, and Applications. Adv. Mater. Sci. Eng. 2015, 2015, 624394. [Google Scholar] [CrossRef]
- Rauwel, P.; Küünal, S.; Ferdov, S.; Rauwel, E. A Review on the Green Synthesis of Silver Nanoparticles and Their Morphologies Studied via TEM. Adv. Mater. Sci. Eng. 2015, 2015, 682749. [Google Scholar] [CrossRef]
- Reller, L.B.; Weinstein, M.; Jorgensen, J.H.; Ferraro, M.J. Antimicrobial Susceptibility Testing: A Review of General Principles and Contemporary Practices. Clin. Infect. Dis. 2009, 49, 1749–1755. [Google Scholar] [CrossRef]
- Balouiri, M.; Sadiki, M.; Ibnsouda, S.K. Methods for in vitro evaluating antimicrobial activity: A review. J. Pharm. Anal. 2016, 6, 71–79. [Google Scholar] [CrossRef] [PubMed]
- Rios, J.L.; Recio, M.C.; Villar, A. Screening methods for natural products with antimicrobial activity: A review of the literature. J. Ethnopharmacol. 1988, 23, 127–149. [Google Scholar] [CrossRef] [PubMed]
- Wang, M.; Zhang, Y.; Wang, R.; Wang, Z.; Yang, B.; Kuang, H. An Evolving Technology That Integrates Classical Methods with Continuous Technological Developments: Thin-Layer Chromatography Bioautography. Molecules 2021, 26, 4647. [Google Scholar] [CrossRef] [PubMed]
- Geoprincy, G.; Saravana, P.; Gandhi, N.N.; Renganathan, S. A novel approach for studying the combined antimicrobial effects of silver nanoparticles and antibiotics through agar over layer method and disk diffusion method. Dig. J. Nanomater. Biostruct. 2011, 6, 1557. [Google Scholar]
- Kadiyala, U.; Kotov, N.A.; VanEpps, J.S. Antibacterial Metal Oxide Nanoparticles: Challenges in Interpreting the Literature. Curr. Pharm. Des. 2018, 24, 896–903. [Google Scholar] [CrossRef] [PubMed]
- Cui, J.; Faria, M.; Björnmalm, M.; Ju, Y.; Suma, T.; Gunawan, S.T.; Richardson, J.J.; Heidari, H.; Bals, S.; Crampin, E.J.; et al. A Framework to Account for Sedimentation and Diffusion in Particle–Cell Interactions. Langmuir 2016, 32, 12394–12402. [Google Scholar] [CrossRef] [PubMed]
- Cho, E.C.; Zhang, Q.; Xia, Y. The effect of sedimentation and diffusion on cellular uptake of gold nanoparticles. Nat. Nanotechnol. 2011, 6, 385–391. [Google Scholar] [CrossRef]
- Giorgi, F.; Macko, P.; Curran, J.M.; Whelan, M.; Worth, A.; Patterson, E.A. Settling dynamics of nanoparticles in simple and biological media. R. Soc. Open Sci. 2021, 8, 210068. [Google Scholar] [CrossRef] [PubMed]
- Hinderliter, P.M.; Minard, K.R.; Orr, G.; Chrisler, W.B.; Thrall, B.D.; Pounds, J.G.; Teeguarden, J.G. ISDD: A computational model of particle sedimentation, diffusion and target cell dosimetry for in vitro toxicity studies. Part. Fibre Toxicol. 2010, 7, 36. [Google Scholar] [CrossRef]
- Krug, H.F. Nanosafety Research—Are We on the Right Track? Angew. Chem. Int. Ed. 2014, 53, 12304–12319. [Google Scholar] [CrossRef]
- Kourmouli, A.; Valenti, M.; van Rijn, E.; Beaumont, H.J.E.; Kalantzi, O.-I.; Schmidt-Ott, A.; Biskos, G. Can disc diffusion susceptibility tests assess the antimicrobial activity of engineered nanoparticles? J. Nanopart. Res. 2018, 20, 62. [Google Scholar] [CrossRef] [PubMed]
- Durán, N.; Nakazato, G.; Seabra, A.B. Antimicrobial activity of biogenic silver nanoparticles, and silver chloride nanoparticles: An overview and comments. Appl. Microbiol. Biotechnol. 2016, 100, 6555–6570. [Google Scholar] [CrossRef]
- Küünal, S.; Visnapuu, M.; Volubujeva, O.; Soares Rosario, M.; Rauwel, P.; Rauwel, E. Optimisation of plant mediated synthesis of silver nanoparticles by common weed Plantago major and their antimicrobial properties. IOP Conf. Ser. Mater. Sci. Eng. 2019, 613, 012003. [Google Scholar] [CrossRef]
- Trinh, N.D.; Nguyen, T.T.B.; Nguyen, T.H. Preparation and characterization of silver chloride nanoparticles as an antibacterial agent. Adv. Nat. Sci. Nanosci. Nanotechnol. 2015, 6, 045011. [Google Scholar] [CrossRef]
- Rauwel, E.; Al-Arag, S.; Salehi, H.; Amorim, C.O.; Cuisinier, F.; Guha, M.; Rosario, M.S.; Rauwel, P. Assessing Cobalt Metal Nanoparticles Uptake by Cancer Cells Using Live Raman Spectroscopy. Int. J. Nanomed. 2020, 15, 7051–7062. [Google Scholar] [CrossRef]
- Küünal, S.; Rauwel, P.; Rauwel, E. Chapter 14—Plant extract mediated synthesis of nanoparticles. In Emerging Applications of Nanoparticles and Architecture Nanostructures; Barhoum, A., Makhlouf, A.S.H., Eds.; Elsevier: Amsterdam, The Netherlands, 2018; pp. 411–446. [Google Scholar] [CrossRef]
- Bonev, B.; Hooper, J.; Parisot, J. Principles of assessing bacterial susceptibility to antibiotics using the agar diffusion method. J. Antimicrob. Chemother. 2008, 61, 1295–1301. [Google Scholar] [CrossRef]
- Balaji, A.; Vellayappan, M.V.; John, A.A.; Subramanian, A.P.; Jaganathan, S.K.; SelvaKumar, M.; Mohd Faudzi, A.A.b.; Supriyanto, E.; Yusof, M. Biomaterials based nano-applications of Aloe vera and its perspective: A review. RSC Adv. 2015, 5, 86199–86213. [Google Scholar] [CrossRef]
- Yousefpoor, Y.; Bolouri, B.; Bayati, M.; Shakeri, A.; Eskandari, Y. The combined effects of Aloe vera gel and silver nanoparticles on wound healing in rats. Nanomed. J. 2016, 3, 57–64. [Google Scholar]
- Kumar, R.; Rauwel, P.; Kriipsalu, M.; Wragg, D.; Rauwel, E. Nanocobalt based (Co@Co(OH)2) sand nanocomposite applied to manganese extraction from contaminated water. J. Environ. Chem. Eng. 2023, 11, 109818. [Google Scholar] [CrossRef]
- De Hoog, G.S.; Dukik, K.; Monod, M.; Packeu, A.; Stubbe, D.; Hendrickx, M.; Kupsch, C.; Stielow, J.B.; Freeke, J.; Göker, M.; et al. Toward a Novel Multilocus Phylogenetic Taxonomy for the Dermatophytes. Mycopathologia 2017, 182, 5–31. [Google Scholar] [CrossRef]
- Quispe, C.; Villalobos, M.; Bórquez, J.; Simirgiotis, M. Chemical Composition and Antioxidant Activity of Aloe vera from the Pica Oasis (Tarapacá, Chile) by UHPLC-Q/Orbitrap/MS/MS. J. Chem. 2018, 2018, 6123850. [Google Scholar] [CrossRef]
- Surjushe, A.; Vasani, R.; Saple, D.G. Aloe vera: A short review. Indian J. Dermatol. 2008, 53, 163–166. [Google Scholar] [CrossRef] [PubMed]
- Alemdar, S.; Agaoglu, S. Investigation of In Vitro Antimicrobial Activity of Aloe vera Juice. J. Anim. Vet. Adv. 2009, 8, 99–102. [Google Scholar]
- Athiban, P.P.; Borthakur, B.J.; Ganesan, S.; Swathika, B. Evaluation of antimicrobial efficacy of Aloe vera and its effectiveness in decontaminating gutta percha cones. J. Conserv. Dent. 2012, 15, 246–248. [Google Scholar] [CrossRef]
- Goudarzi, M.; Fazeli, M.; Azad, M.; Seyedjavadi, S.S.; Mousavi, R. Aloe vera Gel: Effective Therapeutic Agent against Multidrug-Resistant Pseudomonas aeruginosa Isolates Recovered from Burn Wound Infections. Chemother. Res. Pract. 2015, 2015, 639806. [Google Scholar] [CrossRef] [PubMed]
- Ansel, H.C.; Norred, W.P.; Roth, I.L. Antimicrobial Activity of Dimethyl Sulfoxide Against Escherichia coli, Pseudomonas aeruginosa, and Bacillus megaterium. J. Pharm. Sci. 1969, 58, 836–839. [Google Scholar] [CrossRef]
- Arbab, S.; Ullah, H.; Weiwei, W.; Wei, X.; Ahmad, S.U.; Wu, L.; Zhang, J. Comparative study of antimicrobial action of aloe vera and antibiotics against different bacterial isolates from skin infection. Vet. Med. Sci. 2021, 7, 2061–2067. [Google Scholar] [CrossRef]
- Suriati, L.; Mangku, I.G.P.; Rudianta, I.N. The characteristics of Aloe vera gel as an edible coating. IOP Conf. Ser. Earth Environ. Sci. 2018, 207, 012051. [Google Scholar] [CrossRef]
- Ramachandra, C.T.; Rao, P.S. Processing of Aloe vera Leaf Gel: A Review. Am. J. Agric. Biol. Sci. 2008, 3, 502–510. [Google Scholar] [CrossRef]

| SAE-AgNPs (mg/mL) | Inhibition Radius (From Center of the Drop Diffusion Method) in mm | |||
|---|---|---|---|---|
| Escherichia coli | Pseudomonas aeruginosa | Staphylococcus aureus | Streptococcus dysgalactiae | |
| Extract | 0 | 0 | 0 | 0 |
| 0.1 | 0 | 0 | 0 | 0 |
| 0.2 | 8 ± 0.25 | 6 ± 0.25 | 0 | 0 |
| 0.5 | 8 ± 0.15 | 7 ± 0.25 | 0 | 6 ± 0.25 |
| 0.8 | 9 ± 0.2 | 9 ± 0.2 | 5 ± 0.15 | 6 ± 0.1 |
| 1 | 9 ± 0.15 | 9 ± 0.15 | 5 ± 0.1 | 7 ± 0.15 |
| SAE-AgNPs (wt%) | Inhibition Radius (Distance from Gel) in mm | |||
|---|---|---|---|---|
| Escherichia coli | Pseudomonas aeruginosa | Staphylococcus aureus | Streptococcus dysgalactiae | |
| 0 | 0 | 0 | 0 | 0 |
| 0.5 | 2.5 ± 0.25 | 3.5 ± 0.25 | 1.15 ± 0.25 | 1.5 ± 0.25 |
| 1 | 2.5 ± 0.25 | 3.5 ± 0.25 | 1.5 ± 0.25 | 2 ± 0.25 |
| CoNPs (wt%) | Inhibition Radius (Distance from Gel) in mm | ||
|---|---|---|---|
| Escherichia coli | Pseudomonas aeruginosa | Staphylococcus aureus | |
| 0 | 0 | 0 | 0 |
| 0.5 | 3.0 ± 0.25 | 2.0 ± 0.25 | 1.5 ± 0.25 |
| 1 | 4.0 ± 0.25 | 2.5 ± 0.25 | 2.5 ± 0.25 |
Disclaimer/Publisher’s Note: The statements, opinions and data contained in all publications are solely those of the individual author(s) and contributor(s) and not of MDPI and/or the editor(s). MDPI and/or the editor(s) disclaim responsibility for any injury to people or property resulting from any ideas, methods, instructions or products referred to in the content. |
© 2024 by the authors. Licensee MDPI, Basel, Switzerland. This article is an open access article distributed under the terms and conditions of the Creative Commons Attribution (CC BY) license (https://creativecommons.org/licenses/by/4.0/).
Share and Cite
Rauwel, E.; Arya, G.; Praakle, K.; Rauwel, P. Use of Aloe Vera Gel as Media to Assess Antimicrobial Activity and Development of Antimicrobial Nanocomposites. Int. J. Mol. Sci. 2024, 25, 5599. https://doi.org/10.3390/ijms25115599
Rauwel E, Arya G, Praakle K, Rauwel P. Use of Aloe Vera Gel as Media to Assess Antimicrobial Activity and Development of Antimicrobial Nanocomposites. International Journal of Molecular Sciences. 2024; 25(11):5599. https://doi.org/10.3390/ijms25115599
Chicago/Turabian StyleRauwel, Erwan, Geeta Arya, Kristi Praakle, and Protima Rauwel. 2024. "Use of Aloe Vera Gel as Media to Assess Antimicrobial Activity and Development of Antimicrobial Nanocomposites" International Journal of Molecular Sciences 25, no. 11: 5599. https://doi.org/10.3390/ijms25115599
APA StyleRauwel, E., Arya, G., Praakle, K., & Rauwel, P. (2024). Use of Aloe Vera Gel as Media to Assess Antimicrobial Activity and Development of Antimicrobial Nanocomposites. International Journal of Molecular Sciences, 25(11), 5599. https://doi.org/10.3390/ijms25115599

